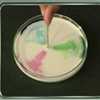

ADVERTISEMENT
ADVERTISEMENT
Aw… Nuts!
While the Squirrel Princess is off searching for a Noodle Nut to complete her rare nut collection. Watch Aw… Nuts! online on your mobile phone, tablet or computer.
Number Of Views
2857 views
Rating: 4.5 / 5
Platform: HTML5 VIDEO
This free online video was built with HTML5. It runs on Chrome, Firefox, Opera, Safari or Internet Explorer 9 or higher. Watch Aw… Nuts! unblocked on any device. Aw… Nuts! online is optimized for use on PC, Android and iOS devices, including tablets and mobile phones. This video plays directly in your browser - no downloads, no registration, no flash and no plugins are needed to view.
Aw… Nuts!
While the Squirrel Princess is off searching for a Noodle Nut to complete her rare nut collection. Watch Aw… Nuts! online on your mobile phone, tablet or computer.
Number Of Views
2,857 views
Rating: 4.5 / 5
Platform: HTML5 VIDEO
This free online video was built with HTML5. It runs on Chrome, Firefox, Opera, Safari or Internet Explorer 9 or higher. Watch Aw… Nuts! unblocked on any device. Aw… Nuts! online is optimized for use on PC, Android and iOS devices, including tablets and mobile phones. This video plays directly in your browser - no downloads, no registration, no flash and no plugins are needed to view.
All Fired Up
Gigi the Jigglebug
The Space Squid Kid
Bubble Trouble
Snow Lie
Too Few Clues
Dressed to Ill
Quit Bugging Me
Super Duper Party Pooper
The Right Fluff
Dem Gems
One Crabby Day
Bossy Bossy Boss
The Chew Chew Train
The Big Bouquet
And What If?
The Blame Game
Safari So Bad
Me, Oh My, Blueberry Pie!
Duckie See, Duckie Do
Baking Buddies
Aw… Nuts!
Mad Mad Mad
The Magic Flower
ADVERTISEMENT
ADVERTISEMENT
Episode 3: D.I.Y. with C.C.B.
Ancient Egypt (Episode 15, Cut the Rope: Time Travel)
Episode 15: Builders Say Cheese
5-9 A Day
CaptainSparklez: Into The Void Episode 2
The Magic Mrs. Tick
Sneevil Genie
Distraction House
Irish Dancing on What Now
The Bulleteers
Billion Dollar Limited
Problem Solved: How To Stop Daydreaming In Class!
Rubik's Cube World Champion
Compass and Map
The Story of 10 Little Pigs
UniKitty: Action Forest
Mouse in the House: Weatherman's Barometer
Talkin' Treehouse - The Ekholms Review The 65 Story Treehouse
I Found Love Jingle
The Oldest Tapir in the World!
Forever Friends Saint Patrick's Day
Sesame Street: Elmo and Whale: Love
Lord of the Fleas - Sneak Peek - Episode 9
100 Percent Movie Night
Silly Smighty Day
Mosa Mack Science Detective: Photosynthesis Answer
What If There Were No Gravity
Episode 5: Not My Flower!
The Muppets: Ringing of the Bells
Cute Bunny Jumping Competition
Mouse in the House: Egg Steamboat
Om Nom Stories: Bakery (Episode 28, Cut the Rope: Unexpected Adventure)
Muppets "Joy To The World"
Climbing Up This Mountain (Counting by 10s up to 100)
Problem Solved: How To Start Your Own Band
Most Pyraminx Solved Underwater
Robot That Solves Rubik's Cubes
Mouse in the House: Fizzing Volcano
100 Hearts: A Time Lapse Challenge
Musical Jokes
Nilanshi Patel: India's Rapunzel
Ep 9 - Adrien's Double Life
The Paper Alphabet
Fences and Gates
Bubbles Beauty Blog
Sandy Dam (Episode 23, Cut the Rope: Unexpected Adventure)
Mouse in the House: DIY Lava Lamp
Mining, Smelting